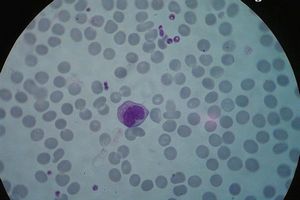

Моноциты повышены
Порой, рассматривая результаты анализов крови, мы недоумеваем: что же значат все эти загадочные выражения типа «уровень эритроцитов» или «СОЭ»? А кое-кто просто готов удариться в панику, увидев надпись типа «моноциты повышены».Давайте же попробуем разобраться хотя бы с последним явлением и выясним, что представляют собой моноциты и чем грозит повышение их уровня в крови человека.
Моноциты – что это?
В любой медицинской энциклопедии можно прочитать, что моноциты – это клетки иммунной системы, являющиеся разновидностью лейкоцитов. Как и все представители этой защитной группы, моноциты борются с различными инфекциямии опухолями, ликвидируют отмершие ткани и растворяют сгустки крови.Местом образования и созревания моноцитов является костный мозг. После выхода из него эти клетки могут до 70 часов циркулировать в крови. Затем они уходят в ткани организма,превращаясь в макрофаги, уничтожающие погибшие ткани и болезнетворные бактерии.
Поэтому несложно догадаться, что увеличение числа этих клеточек (а соответственно, и диагноз «моноциты повышены») чаще всего наблюдается при протекании различных инфекций. а также при некоторых заболеваниях крови. Считается, что норма содержания моноцитов у взрослого здорового человека и у ребенка старше тринадцати лет – не более 8 процентов от общего числа всех лейкоцитов.
Почему повышается уровень моноцитов?
Если в лаборатории было определено, что моноциты повышены, то пациент будет оправлен к лечащему врачу для выяснения причин этого состояния. Повышение содержания этих кровяных телец (или моноцитоз) особенно часто встречается при протекании инфекционных заболеваний. Такое состояние может возникнуть при инфекционном мононуклеозе, малярии, токсоплазмозе, бруцеллезе или сифилисе.
Кроме того, считается, что повышение моноцитов является одним из признаков таких тяжело протекающих процессов, как сепсис, лейкоз, туберкулез. Нередко моноцитоз возникает принекоторых злокачественных заболеваниях лимфатической системы.
Моноциты повышены у ребенка?
Стоит отметить, что норма содержания моноцитов в крови ребенка в процентном отношении несколько отличается от подобных показателей у взрослого человека. Обычно она колеблется в пределах 2–7 процентов от общего числа лейкоцитов.
Для детей повышение уровня моноцитов характерно в период выздоровления после перенесения острых инфекций. Однако такое состояние может возникать и при болезнях крови или туберкулезе. Поэтому в таких случаях ребенку нередко назначают дополнительные исследования на наличие того или иного заболевания, которое могло бы стать причиной моноцитоза.
Повышенные моноциты в крови
Общий анализ крови – одно из самых распространенных лабораторных исследований. Его назначают практически при любых заболеваниях, но далеко не всегда у доктора есть возможность и желание подробно объяснять, что значит то или иное изменение лейкоцитарной формулы крови, почему оно возникло и чем опасно для больного. Например, повышенные моноциты в крови у взрослого встречаются очень часто и иногда свидетельствуют об очень серьезных проблемах со здоровьем.
Функции моноцитов
Моноциты относятся к одному из подвидов лейкоцитов – белых кровяных телец, основная роль которых – защита человеческого тела от чужеродных организмов, погибших и недифференцированных клеток.
Моноциты или тканевые макрофаги составляют примерно 3-9% от общего числа лейкоцитов, они образуются в костном мозге, затем поступают в кровь, где выполняют свою основную функцию – уничтожение вредоносных клеток, а примерно через 48-72 часа моноциты перемещаются в ткани, где также продолжают уничтожать «неправильные» клетки. Несмотря на относительно небольшое количество моноцитов в общей лейкоцитарной формуле, переоценить их значение для организма трудно: благодаря своим крупным размерам, фагоциты способны захватывать и уничтожать крупные чужеродные агенты: бактерии, вирусы и грибы, а также переваривать погибшие клетки. Во время циркуляции в периферической крови моноциты активно борются с любыми вредоносными микроорганизмами, попавшими в человеческий организм, предотвращая большинство вирусных и бактериальных заболеваний. После попадания в ткани фагоциты начинают выполнять не менее важную функцию – они выделяют цитокины, вещества, которые уничтожают опухолевые клетки и внутриклеточных паразитов.
Повышение моноцитов в крови взрослого возникает при инфекционных заболеваниях, когда в крови слишком много вредоносных бактерий или вирусов и организм не может с ними справиться, и при появлении в организме большого количества недифференцируемых клеток, возникающих при росте недоброкачественных новообразованиях.
Читать ещё Моноциты – норма
Причины повышения моноцитов в крови у взрослого
Повышение моноцитов – моноцитоз, может быть относительным и абсолютным. Относительный моноцитоз – это увеличение процентного соотношения моноцитов в общей лейкоцитарной формуле. Незначительное повышение моноцитов встречается чаще всего при инфекционных заболеваниях и свидетельствует о воспалительном процессе, протекающем в организме.
Абсолютный моноцитоз возникает тогда, когда общее количество моноцитов в крови взрослого превышает 0,7*10 9/л. У детей этот показатель не является постоянным и зависит от возраста.
Причинами моноцитоза могут быть:
1. Острые инфекционные заболевания -незначительное увеличение моноцитов возникает при и после любой вирусной или бактериальной инфекции или воспалительного процесса в организме. При вирусных и легких бактериальных инфекциях – ОРВИ, простуде, ангине и так далее, моноцитоз не выраженный, сопровождается другими изменениями в лейкоцитарной формуле и быстро проходит по мере выздоровления, но может сохраняться еще несколько недель после исчезновения клинических признаков.
2. Хронические воспалительные процессы – стойкое повышение моноцитов в анализах крови возникает при таких заболеваниях как туберкулез, инфекционный эндокардит, сифилис, язвенный колит и так далее.
3. Грибковые инфекции – тоже сопровождаются повышением количества моноцитов;
4. Аутоиммунные процессы и злокачественные опухоли – иногда стойкое повышение уровня моноцитов свидетельствует о скрыто протекающих аутоиммунных заболеваниях: системной красной волчанке, ревматоидном артрите и других или б имеющихся в организме злокачественных опухолях.
5. Заболевания крови – лейкозы, лимфогранулематозы, лимфомы и другие болезни кроветворной системы также вызывают увеличение количества моноцитов, причем как относительное, так и абсолютное.
Что делать при моноцитозе
Повышенные моноциты – это всегда повод задуматься о своем здоровье. Даже незначительное увеличение числа фагоцитов должно насторожить врача и пациента. Больной должен обязательно еще раз сделать общий анализ крови и при повторном повышении моноцитов, пройти дополнительные обследования и выяснить причину моноцитоза.
Читать ещё Болит зуб после пломбирования
Ответ: Все об анализах и прививках
Плохо, что весь анализ не написали, даже если что-то Вам кажется нормой.
Моноцитоз характерен для фазы выздоровления после острых инфекционных заболеваний. Однако при туберкулёзе, сифилисе и ещё куче заболеваний моноциты тоже могут быть повышены.
А вот СОЭ высокая, не знаю какая была, может и снижается. Но больше похоже на наличие инфекции и в данный момент.
Ответ: Все об анализах и прививках
Спасибо!
Пишу Вам весь анализ:
гематокрит-34.3
гемоглобин-10.8
эритроциты-5.11
MCV(ср. объем эритр.)-67.1
MCH(ср. содер. Hb в эр.)-21.1
MCHC(ср.конц. Hb в эр.)-31.5
Тромбоциты-276
Лейкоциты-10.03
Палочкоядерные нейтроф.-5
Нейтрофилы сегментояд.-39
нейтрофилы-44
лимфоциты-42
моноциты-13
эозинофилы-1
базофилы-0
СОЭ-28.
Педиат говорит, что легкие чистые, а вот кашель очень сильно похож на аллергический, могут ли такие показатели говорить о наличии аллергии?
Ответ: СРОЧНЫЕ ВОПРОСЫ. Задаём в этой ветке!
Здравствуйте! Подскажите пожалуйста: нам 3 года 9 месяцев, анализ крови от 10.11 г - СОЭ 20, эозинофилы 5,7, лейкоциты 7,2, моноциты 9,5, моноциты абс.к-во 0,7. До этого сдавали неделю назад - СОЭ 30, эозинофилы 2,8, лейкоциты 11.4, моноциты 12,0, моноциты абс.кол-во 1,4. Нас лечили от фалликулярной ангины антибиотиком вильпрофен-салютат 5 дней + супрастин (т.к. возможна аллергия на пенецилин). Подскажите по анализу. Нас можно выписывать или еще нет ?
Ответ: СРОЧНЫЕ ВОПРОСЫ. Задаём в этой ветке!
Анализ не является абсолютным показателем для выписки. Если сохраняется интоксикация, то о выписке речи не может идти.
То, что Вы пишите говорит лишь о том, что подсчёт клеток производился не глазом, а аппаратом. Т.к. глаз не может насчитать 2.8% эозинофилов. Глазом считают 100 клеток, сколько из них будет эозинофилов, столько это и будет процентов. Как у них неровные числа вышли. Недостоверно.
Ещё. Никогда не выдирайте из анализа показатели, которые на Ваш взгляд не укладываются в графу нормы. Аназил крови - картина комплексная, по паре клеток я ничего Вам не смогу пояснить.
Ответ: Все об анализах и прививках
Уважаемый доктор!
Скажите, пожалуйста, что означает показатель #LYM 4.3 Н 10 9/1 в анализе крове ребёнка год и 10 месяцев? Просто, в скобках указана норма (1.2-3.5), значет у нас повышен?
Остальные показатели:
WBC: 9.6
RBC: 4.86
HGB: 132
HCT: 372
PLT: 338
MCV: 76
MCH: 27.2
MCHC: 355
СОЭ 5мм
RDW 13.4%
PCT 271
MPV 8
PDW 14%
LYM 45.4%
MON 5% #MON 0.4
GRA 49.6% #GRA 4.9
Ответ: Железодифицитная анемия, низкий гемоглобин. Читаем и спрашиваем ТУТ.
Доктор, прокомментируйте, пожалуйста, результаты анализов крови (сдавали 3 раза):
Кровь сдавали 3 раза 30.08.08, 18.09.08 и 15.11.08
Результаты соответственно:
Гематокрит 32,2% 31,4 36,0
Гемоглобин 10,6 г/дл 10,5 11,7
Эритроциты 3,61 млн/мм3 3,75 4,39
МСV 89,0 фл 83,6 82,0
MCH 29,3 пг 27,9 26,6
МСНС 32,8 33,3 32,4
Тромбоциты 653 тыс/мкл 560 634
Лейкоциты 6,6 тыс/мкл 7,59 6,6
Нейтрофилы 20,2% 20 19,1
Лимфоциты 64,3% 68 62,7
Моноциты 6% 5 9,6
Эозинофилы 8,9% 6 7,8
Базофилы 0,6% 0 0,8
СОЭ 10 мм/ч 5 4
Объясните, пож, с чем связан повышенный уровень тромбоцитов у ребенка (мальчик, 5,5 мес (2.06.08 ДР))?
Неск.раз пересдавали из-за повышенных тромбоцитов.
Первый раз получили направление на кровь перед прививкой.
Ребенок полностью на ГВ.
Достаточно быстро набираем вес:
рожд - 4200
1 мес - 5300
2 мес - 6900
3 мес - 8000
4 мес - 9100
5 мес - 9600
Нам предстоит в ближайшее время поставить АКДС и 2-ю Полиомелит.
Не являются ли данные анализы крови противопоказанием к вакцинации?
Необходимо ли корректировать уровень гемоглобина препаратами железа?
Ответ: Железодифицитная анемия, низкий гемоглобин. Читаем и спрашиваем ТУТ.
anutavid. Гемоглобин неплохой. Тромбоциты высоковаты. Возможно жидкости не хватает.
Советую проверить агрегацию тромбоцитов. Если она не повышена, то можно спать спокойно. А если повышена, придётся корректировать, чтоб всё эти 600 тысяч не склеились в тромбы.
Ответ: Анализ крови у детей до полугода
Пожалуйста, помогите разобраться, что значит наш анализ. Нам 4, 5 месяца. Можно ли делать первую АКДС. или отвод.
Лейкоциты 9,40
Эритроциты 3,90
Гемоглобин 118,0Гематокрит 33,60
Средний объем эритроцитов 86,20
Тромбоциты 545,00
Сегментоядерные 10,0
Эозинофилы 3,0
Базофилы 1,0
Лимфоциты 80,0
Моноциты 5,0
Плазматия. клетки 0
СОЭ 2,0
Заранее благодарна.
Ответ: Анализ крови у детей до полугода
Здравствуйте. еще раз доктор.
Я по поводу нашей нейтропинии, выше писала наш анализ крови.
В районной поликлинике нам назначили принимать витамины курсом 3 недели:
1. фолиевая кислота 1/3 таблетки 2 раза в день
2. вит Е в масле 3 кап 2 раза в день
3. вит В6 3 кап 1 раз в день
Врач сказала, что должно все восстановиться. Как вы считаете целесообразна ли эта профилактика.
Напомню, мы на ГВ и я сама принимаю витамины Элевит, не много ли ребенку поступает витаминчиков. Вы не подумайте, я не в коем случае не жалею, просто не будет ли лишним.
Заранее спасибо за ответ. yes3:
Ответ: Анализ крови у детей до полугода
помогите! наша педиатр сказала, что анализ крови не просто плохой, а ужасный. но Вам я доверяю больше:
WBC: 13.6 H
RBC: 3.79 L
HGB: 105 L
HCT. 277
PLT: 436
PCT. 359
MCV: 73
MCH: 27.7
MCHC: 379
RDW: 16.0
MPV: 8.2
PDW: 13.2
анизоцитоз (++)
микро-; пойкилоцитоз (+)
n - 3
с - 15
э - 2
мои - 12
л - 67
пл. кл - 1
СОЭ - 33
полихроматофильн. Er 1-2
Что с нами. в 1 месяц СОЭ - 6, HGB - 110
Ответ: Анализ крови у детей до полугода
katsiaryna. Нашла какими словами пугать, безобразие.
анализ не идеален. Признаки железодефицитной анемии, которая может быть и анемией воспаления, т.к. признаки воспаления в крови есть, в виде лейкоцитоза и повышения СОЭ. Смущает то, то палочкоядерные лимфоциты в норме. Возможно инфекция вирусная или бактериальна, но в остром периоде.
Почему пошли сдавать анализ? Не было ли беспокойства ребёнка. Лихорадки. Увеличения лимфоузлов. Насморк, отит ?
Источники: http://www.happy-giraffe.ru/community/33/forum/post/6798/, http://onwomen.ru/povyshennye-monocity-v-krovi.html, http://detstvo.ru/forum/voprosy-pediatru/8566-analiz-krovi-3-print.html
Комментариев пока нет!
